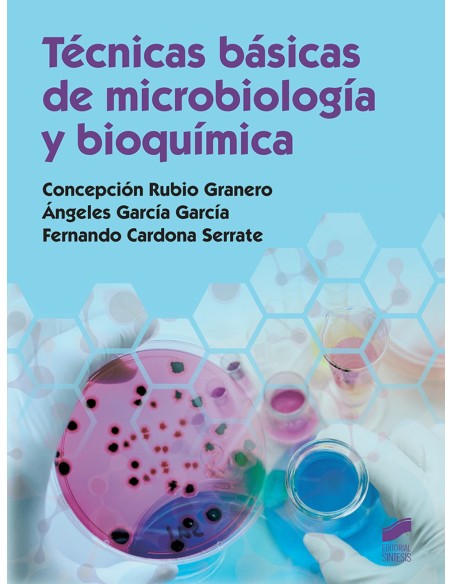
TECNICAS BASICAS DE MICROBIOLOGIA Y BIOQUIMICA

Carrito
No hay más artículos en su carrito
TECNICAS BASICAS DE MICROBIOLOGIA Y BIOQUIMICA
SINTESIS EDITORIAL
583163
Últimas unidades en stock
47,50 €
Impuestos incluidos
TECNICAS BASICAS DE MICROBIOLOGIA Y BIOQUIMICA
Las empresas compiten desde el convencimiento de que los mejores productos son los que alcanzan la cima en el mercado. En el sector químico agroalimentario, sanitario, etc., se toma conciencia de la necesidad de garantizar la calidad de sus productos desde el origen, pasando por su procesado hasta llegar al servicio al cliente. La microbiología y la bioquímica son dos disciplinas de interés para los futuros técnicos en operaciones de laboratorio. En este libro, además de los contenidos básicos descritos en el currículo, se desarrollan los conceptos de química y biología necesarios, así como otros temas elementales, para el desarrollo del trabajo en el laboratorio. Además, en todos los capítulos se motiva al alumno para la lectura, el autoaprendizaje, la observación y la investigación, herramientas que deben acompañar a un buen técnico de laboratorio en el desempeño de sus tareas.
- paginas
- 330
- encuadernacion
- TAPA BLANDA O BOLSILLO
- espesor
- 16
- altura
- 260
- ancho
- 190
1 Artículo
9788490774779
No hay comentarios